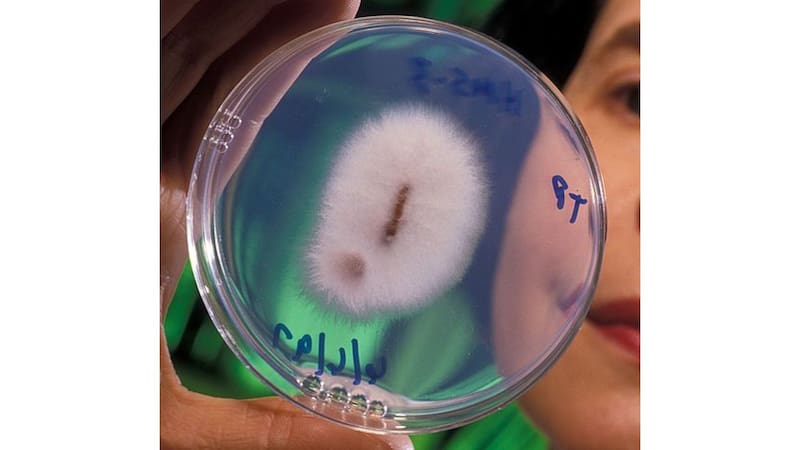
El hallazgo del siglo: encontraron una planta que puede producir oro y puede crecer en cualquier casa

Desde la antigüedad, la humanidad ha soñado con convertir materiales comunes en oro. Esta aspiración, que dio origen a leyendas como la piedra filosofal, ahora podría estar más cerca de lo real gracias a un hallazgo científico reciente.
El descubrimiento fue liderado por el equipo de la Commonwealth Scientific and Industrial Research Organisation (CSIRO) en Australia y se publicó en la revista científica Nature Communications.
El estudio que descubrió que un hongo produce oro
Un grupo de investigadores descubrió que un hongo, presente de forma natural en muchos entornos y cultivable en casa, tiene la capacidad de producir oro puro a partir de compuestos minerales.
El estudio abre una vía completamente nueva en la obtención del oro, al demostrar que no se necesitan grandes explotaciones ni maquinaria pesada, sino la acción de un organismo vivo. El protagonista: el Fusarium oxysporum, un hongo conocido por afectar a ciertas plantas, pero ahora reconocido por un poder oculto que cambia por completo su imagen.
¿Qué es el Fusarium oxysporum, el hongo que genera oro?
El Fusarium oxysporum es un hongo de amplia distribución en suelos a nivel global. Hasta el momento, había sido objeto de preocupación para los agricultores debido a su capacidad para dañar cultivos como el tomate y el plátano.
No obstante, la ciencia ha revelado recientemente una habilidad sorprendente: puede transformar minerales en partículas de oro.
Este hongo tiene la capacidad de absorber metales como hierro, aluminio y calcio y en el proceso, genera nanopartículas de oro en su superficie, explica el investigador Tsing Bohu, líder del experimento.
Para validar esta afirmación, se expuso al hongo a polvo mineral extraído de un meteorito proveniente del cinturón de asteroides. La reacción biológica fue no solo observable, sino también cuantificable a nivel microscópico.
Este fenómeno se inscribe en lo que se conoce como ciclo biogeoquímico del oro, un proceso natural en el que ciertos organismos desempeñan un papel crucial en la formación y acumulación de este metal precioso en la corteza terrestre.
El proceso biológico del hongo que transforma el oro
A diferencia de otros métodos de extracción de oro que requieren calor, presión y productos químicos nocivos, el proceso que involucra al Fusarium oxysporum es completamente biológico.

Según el estudio, este hongo produce enzimas que alteran el entorno mineral, facilitando la precipitación y acumulación del oro en forma de iones, que se transforma nuevamente en oro sólido.
Los investigadores han observado que este proceso se repite en presencia de ciertas sales minerales, lo que sugiere que el hongo tiene la capacidad de reconocer las partículas de oro y actuar sobre ellas de manera específica.
“El comportamiento del Fusarium es fundamental para comprender cómo se forma el oro en la naturaleza y puede ser aprovechado para replicar dicho proceso”, afirmaron desde CSIRO. Además, se descubrió que los hongos del orden Hypocreales, al que pertenece el Fusarium, son más prevalentes en áreas con alto contenido de oro, lo que refuerza la hipótesis de que estos organismos desempeñan un papel crucial en la bioprecipitación del metal.
¿Es posible cultivar en casa un hongo que produce oro?
Aunque pueda parecer un concepto sacado de una novela de ciencia ficción, la respuesta es afirmativa. En teoría, cualquier persona con un entorno estéril y ciertos minerales podría llevar a cabo este proceso en su hogar o en un laboratorio improvisado.
El hongo Fusarium oxysporum no requiere instalaciones industriales ni reactores complejos, lo que lo convierte en un candidato ideal para desarrollos a pequeña escala. Este avance se enmarca en un campo emergente conocido como minería metabólica, que investiga cómo utilizar microorganismos para extraer minerales valiosos sin perjudicar el medio ambiente.
Se trata de una alternativa limpia, sin explosiones, sin un uso intensivo de agua y sin grandes cantidades de residuos. “En condiciones controladas, el hongo puede generar pequeñas cantidades de oro. Es un enfoque revolucionario”, indicó Bohu.












